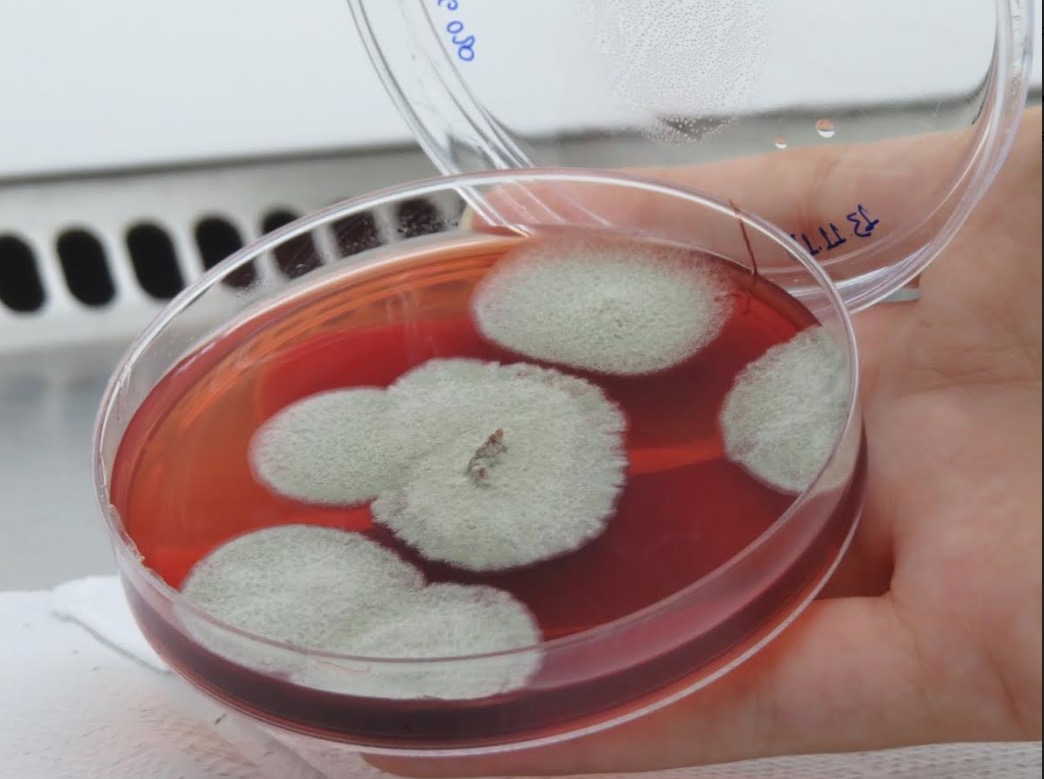
Fungos encontrados no rio Amazonas podem auxiliar no combate ao câncer

Manaus/AM - Projeto desenvolvido pelo Grupo de Pesquisa em Metabolômica e Espectrometria de Massas da Universidade do Estado do Amazonas (UEA), em parceria com o Instituto Gonçalo Moniz da Bahia (Fiocruz – BA), com o apoio da Fundação de Amparo à Pesquisa do Estado do Amazonas (Fapeam), por meio do Programa Amazonas Estratégico, pretende descobrir se linhagens de fungos filamentosos encontrados no fundo do rio Amazonas que produzem substâncias contra os cânceres de fígado, mama, colo do útero e sangue (leucemia).
O estudo tem a finalidade de investigar o potencial biológico desses microrganismos, por meio de ensaios de atividade antioxidante, microbiológica e citotóxica. A descoberta de novos compostos bioativos é o primeiro passo para auxiliar no desenvolvimento de novos medicamentos capazes de combater a proliferação de células tumorais.
O coordenador do projeto e pós-doutor em Química Orgânica e professor da Universidade do Estado do Amazonas, Héctor Koolen, explica que os resultados alcançados por meio dos estudos com os fungos filamentosos devem fomentar a pesquisa de base na área de química e farmácia no Estado do Amazonas, além de descobrir as potencialidades da biodiversidade amazônica, bem como a necessidade da preservação do ecossistema.
“A pesquisa especificamente com esses fungos está na etapa microbiológica, ou seja, é a fase em que os fungos estão sendo propagados e em seguida preservados. Entretanto, os estudos laboratoriais identificaram moléculas com potencial biotecnológico em fungos endofíticos e em plantas da região”, informou Héctor.
Processo
Ele explica que para identificar se é possível isolar essas substâncias e utilizá-las farmacologicamente contra o câncer serão feitas a caracterização química de 110 linhagens de amostras desses novos microrganismos, verificando se esses compostos são responsáveis pela atividade antitumoral.
“A produção de medicamentos será possível se ao longo do processo de estudos as substâncias forem aprovadas nos testes pré-clínicos (in vivo) com camundongos. Mas não basta que a molécula seja ativa, ela necessita não ser prejudicial ao restante do organismo. Isso será avaliado neste projeto de modo a fomentar o interesse de alguma indústria farmacêutica para as sínteses e estudos clínicos (ensaios em seres humanos). Vale ressaltar que o processo para que um candidato vire fármaco é custoso, e leva em média 15 anos para a aprovação final. Esse projeto visa fomentar possíveis estudos clínicos”, ressaltou.
Objetivo
Desde 2015, o grupo de pesquisa estuda linhagens de fungos, com o trabalho de identificar, catalogar e preservar as estirpes.
Para Koolen, a principal meta do projeto é a descoberta de uma molécula orgânica com potencial anticâncer in vitro e in vivo que seja produzido por um fungo do Amazonas. “Iniciativas na área como a que esse projeto se propõe constituem o primeiro, e bastante importante, passo para o apoio estratégico ao desenvolvimento econômico-ambiental do Estado do Amazonas”.
Segundo Héctor, a pesquisa se justifica pela necessidade de adquirir um amplo conhecimento em relação ao potencial do Amazonas em gerar um novo candidato a insumo farmacêutico no combate ao câncer. “O Estado do Amazonas por toda sua riqueza de recursos naturais constitui um depósito de moléculas bioativas ainda por descobrir. Infindáveis espécies de fungos, muitas delas ainda nem descritas, habitam o nosso Estado e podem fornecer novas moléculas com atividade anticâncer”, completa Koolen.

Aviso